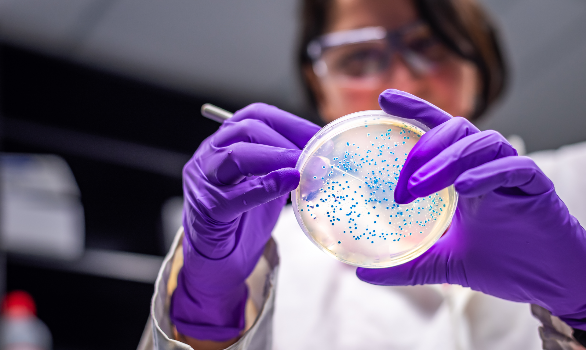

Диагностика будущего: конференция в Иркутске
14–15 августа в Иркутске состоится научная конференция «Медицинская лабораторная диагностика — область междисциплинарного взаимодействия». Мероприятие приурочено к 35-летию со дня образования некоммерческого партнерства «Специалисты лабораторной службы Иркутской области».
Среди основных тем конференции: современные инновационные технологии для диагностики инфекционных заболеваний, актуальные проблемы микробиологической диагностики, контроль качества на всех этапах лабораторной диагностики и т.д. Участники получат возможность обменяться опытом, обсудить новейшие технологии и современные методы исследований.
Параллельно с конференцией пройдет специализированная выставка, в которой примет участие ГК «ДИАКОН». Наши эксперты будут рады проконсультировать участников по вопросам лабораторной диагностики и продемонстрировать лучшие решения, предлагаемые компанией.
Ждем 14-15 августа по адресу: г. Иркутск, ул. Байкальская, 279, ГК "Байкал Бизнес Центр" (Конференц-зал).
Ко всем новостям
Сервисная служба ГК «ДИАКОН» успешно завершила проведение ежеквартальных учебных мероприятий для спе...

25–26 августа в Диаконе побывали самые важные гости — дети сотрудников.

ГК «ДИАКОН» — участник IV международного научно-практического форума «Огнестрельная рана. Хирургия п...

ДИАКОН выступила партнером 20-й Всероссийской конференции с международным участием «Проблема инфекци...

Сегодня международный день педиатра!

Ксения Егорова, директор по правовым вопросам ГК «ДИАКОН», приняла участие в бизнес-завтраке по фарм...
